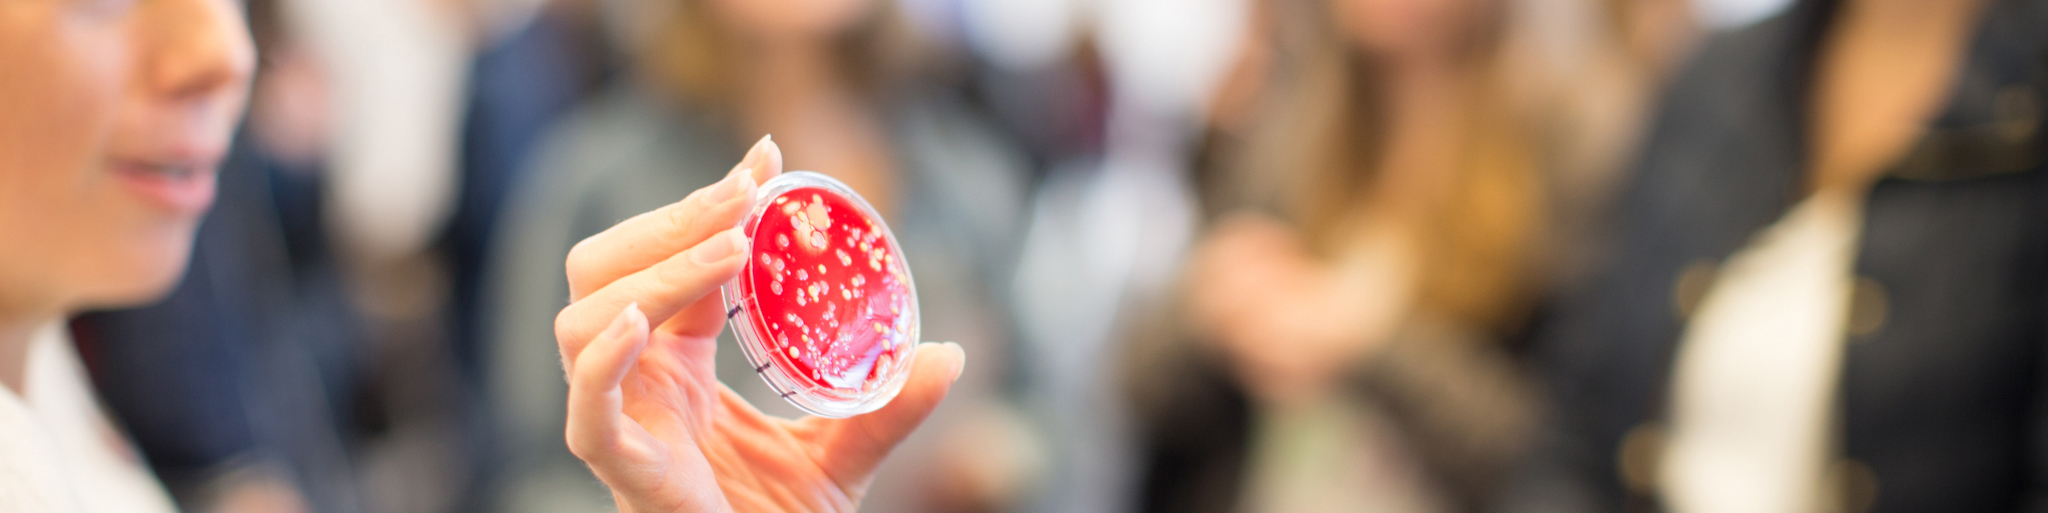

ForskarFredag – möt en forskare
ForskarFredag skapar möten mellan forskare och allmänheten, lyfter forskningens betydelse i vår vardag och för samhället och visar unga att forskning är en möjlig karriärväg.
ForskarFredag 2024 - låna en forskare!
För gymnasieelever i Jönköpings län erbjuder vi i år en möjlighet att låna en forskare fysiskt eller digitalt den 23-27 september. I år har vi fokuserat på att låna ut forskare inom medicin, hälsa och vård. En forskare berättar om hur det är att arbeta som forskare, varför hen blev forskare och om sina forskningsresultat. Syftet är att skapa en nära dialog mellan elever och forskare, så samtalet styrs av eleverna i hög utsträckning. Ett besök varar ca 40-60 minuter.
Se hela inbjudan via denna länk. pdf, 520.1 kB, öppnas i nytt fönster.
Är du lärare och vill ta med din klass till vår forskarmässa i Campus Arena?
Anmäl er här! Länk till annan webbplats, öppnas i nytt fönster.
ForskarFredag bjuder på spännande möten med forskare inom olika områden, och äger rum på samma dag i hela Europa. Målgruppen är den breda allmänheten med en särskild inriktning mot barn och unga.
Researchers’ Night arrangerades första gången 2005 runt om i Europa och på en rad orter i Sverige. Sedan 2006 har de svenska aktiviteterna knutits samman under det gemensamma namnet ForskarFredag och koordinerats av föreningen Vetenskap & Allmänhet, VA Länk till annan webbplats, öppnas i nytt fönster..
ForskarFredag i Jönköping sker i samarbete mellan Jönköping University, Region Jönköpings län och Europa Direkt Jönköpings län.

Om ForskarFredag
Den fjärde fredagen i september är utlyst som Researchers' Night av EU-kommissionen. Runt om i hela Europa erbjuds hundratals aktiviteter som visar hur spännande och kul forskning är. I Sverige kallas dagen för ForskarFredag.
Läs mer om Forskafredag här: Länk till annan webbplats, öppnas i nytt fönster.

ForskarFredag 2019
"Låna en forskare", där skolorna fick låna en forskare var en populär aktivitet under 2019 års ForskarFredag. Forskning kring ämnen som svensk historia och Karl XII, digital stress i arbetslivet och forskning kring självskadebeteende var några av programpunkterna på ForskarFredag 2019.